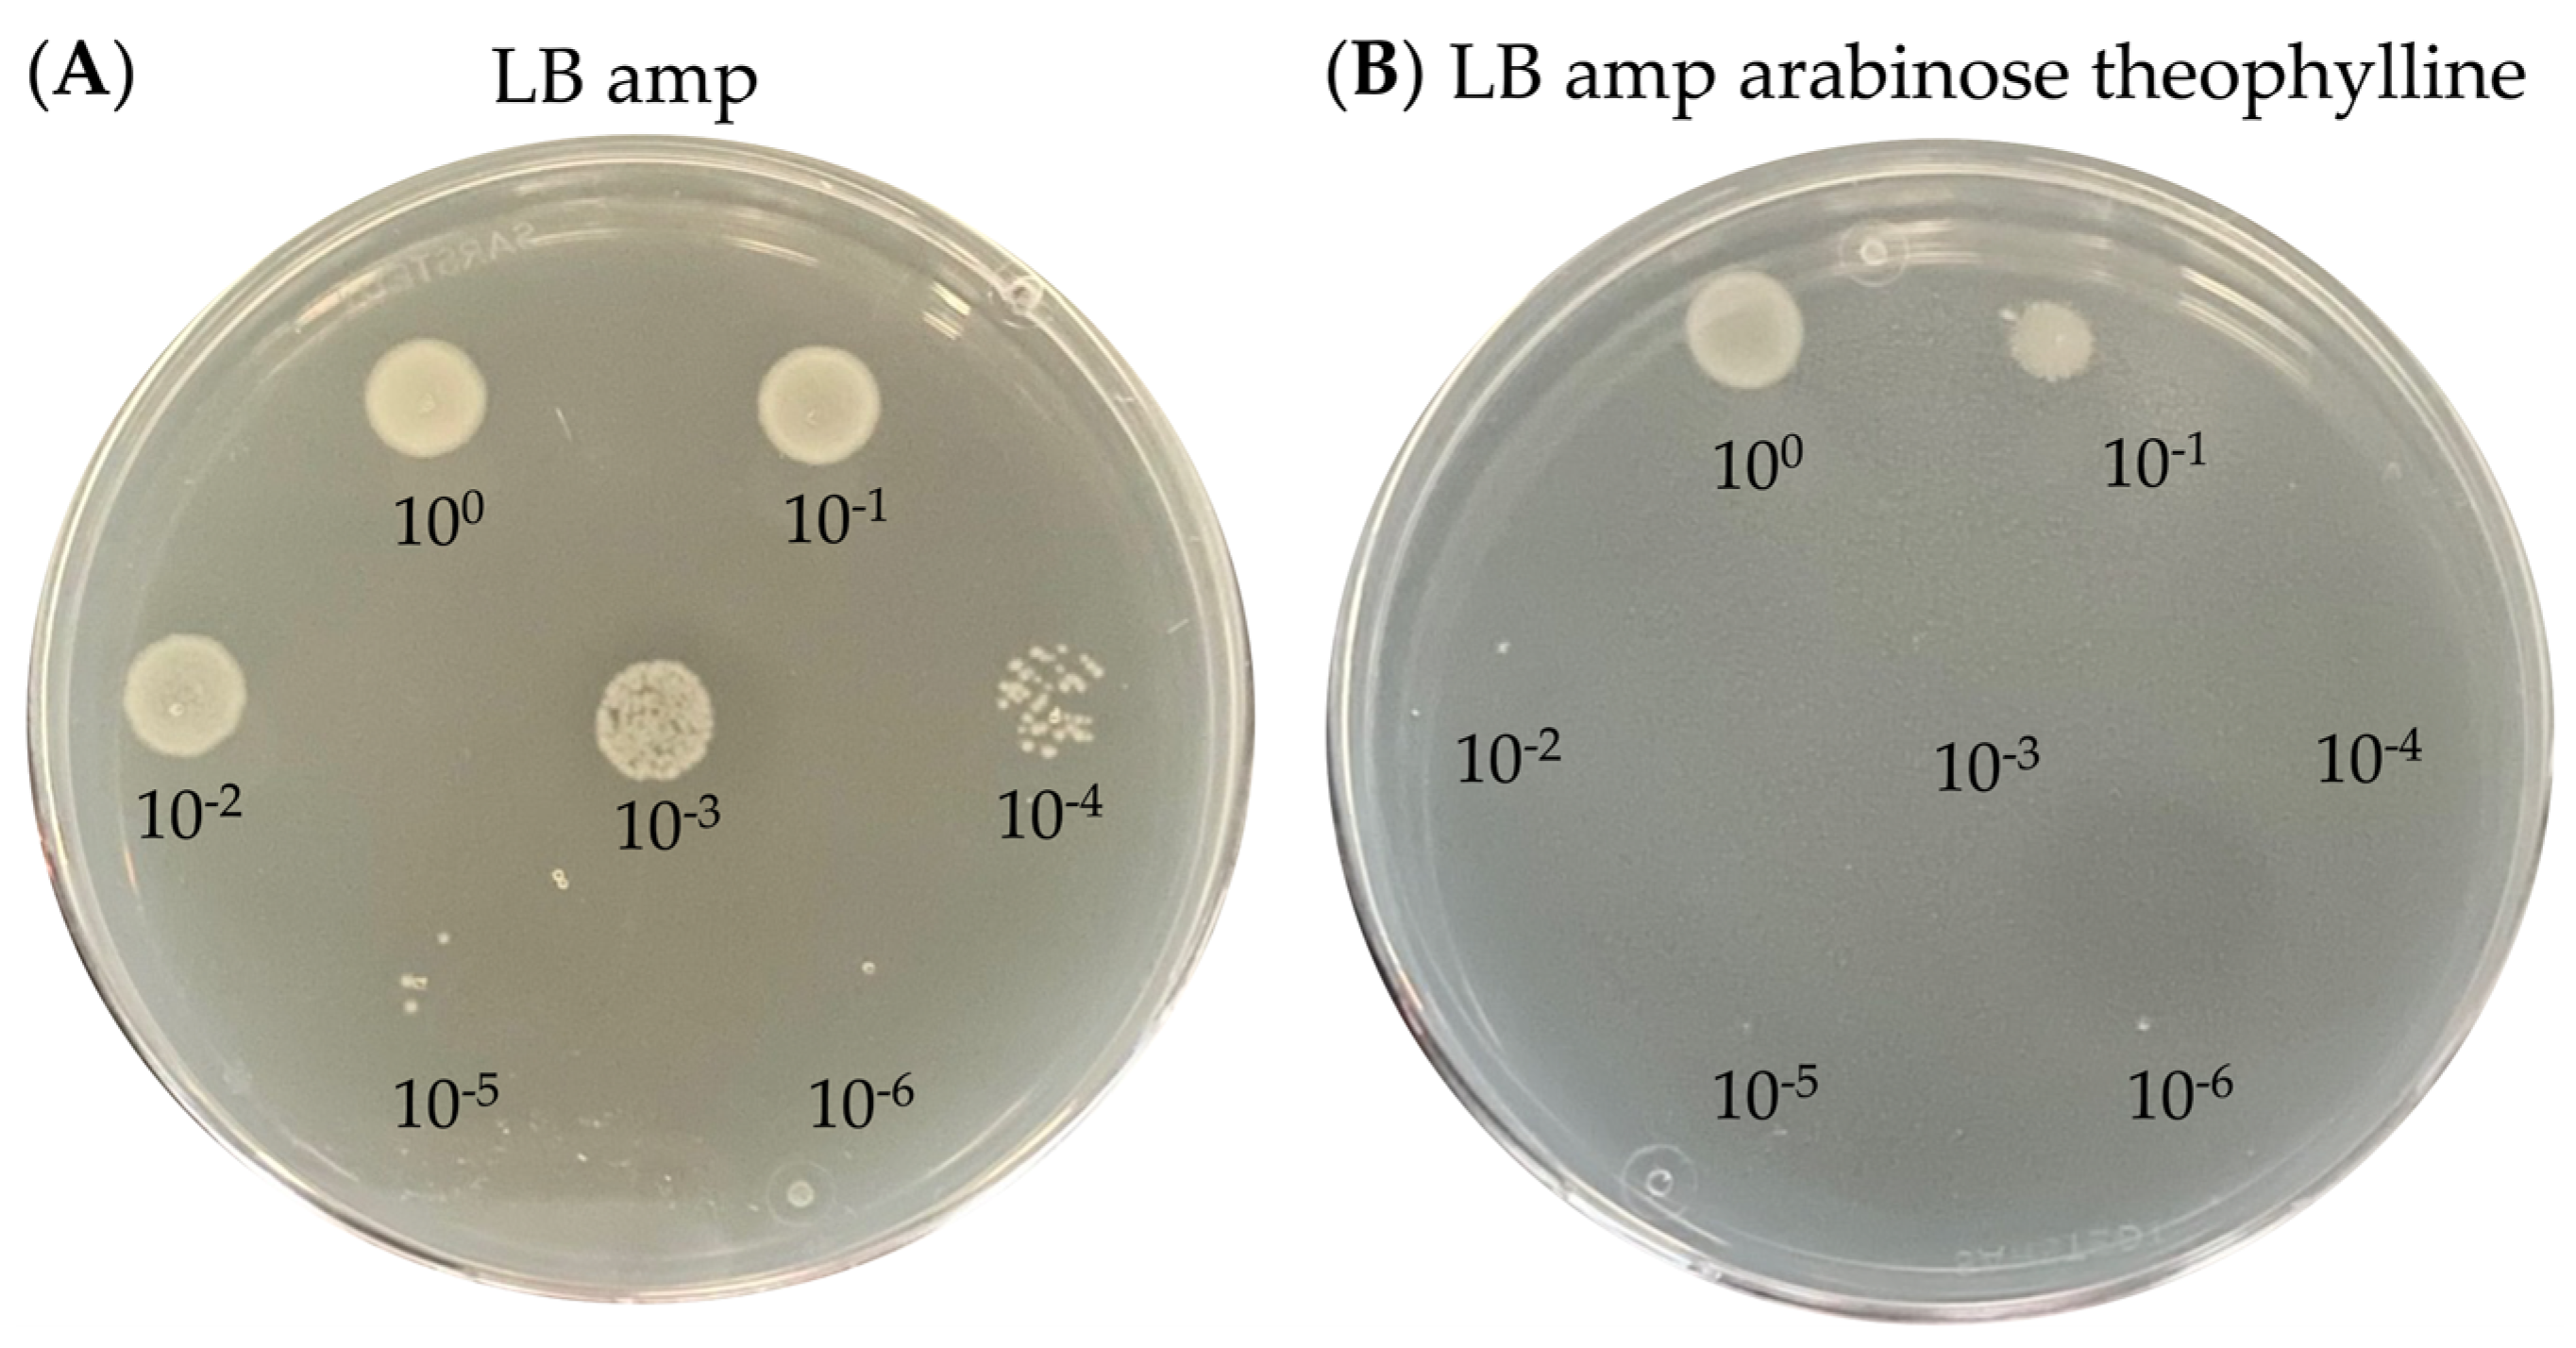
Toxins 15 00508 g006 Toxins 15 00508 g006

A Multi-Layer-Controlled Strategy for Cloning and Expression of Toxin Genes in Escherichia coli
Abstract
1. Introduction
2. Results and Discussion
2.1. Choice of Toxins
2.2. Design of Different Multi-Control Systems
2.3. Cloning Efficiency of the Different Systems
2.4. Assessing Toxicity upon Inducing Gene Expression
2.4.1. Combination of the PfdeA Promoter with the RSB12 Riboswitch
2.4.2. Combination of the Ptac Promoter with the RStheo Riboswitch
2.4.3. Combination of the PBAD Promoter with the RStheo Riboswitch
2.5. Applicability of the Ptac—Theophylline System for Protein Production
3. Conclusions
4. Materials and Methods
4.1. Cloning and Transformation
4.1.1. PfdeA Promoter
4.1.2. Tac Promoter
4.1.3. Arabinose Promoter
4.2. Spot Test
4.3. Plate Reader Experiment
4.4. Expression Test
4.5. qPCR
4.6. Protein Purification
Supplementary Materials
Author Contributions
Funding
Institutional Review Board Statement
Informed Consent Statement
Data Availability Statement
Acknowledgments
Conflicts of Interest
References
- Sezonov, G.; Joseleau-Petit, D.; D’Ari, R. Escherichia coli physiology in Luria-Bertani broth. J. Bacteriol. 2007, 189, 8746–8749. [Google Scholar] [CrossRef] [PubMed]
- Pope, B.; Kent, H.M. High efficiency 5 min transformation of Escherichia coli. Nucleic Acids Res. 1996, 24, 536–537. [Google Scholar] [CrossRef] [PubMed][Green Version]
- Rosano, G.L.; Ceccarelli, E.A. Recombinant protein expression in Escherichia coli: Advances and challenges. Front. Microbiol. 2014, 5, 172. [Google Scholar] [CrossRef] [PubMed]
- Bernard, P.; Couturier, M. Cell killing by the F plasmid CcdB protein involves poisoning of DNA-topoisomerase II complexes. J. Mol. Bio. 1992, 226, 735–745. [Google Scholar] [CrossRef]
- Bunker, R.D.; McKenzie, J.L.; Baker, E.N.; Arcus, V.L. Crystal structure of PAE0151 from Pyrobaculum aerophilum, a PIN-domain (VapC) protein from a toxin-antitoxin operon. Proteins 2008, 72, 510–518. [Google Scholar] [CrossRef]
- Guzman, L.M.; Belin, D.; Carson, M.J.; Beckwith, J. Tight regulation, modulation, and high-level expression by vectors containing the arabinose PBAD promoter. J. Bacteriol. 1995, 177, 4121–4130. [Google Scholar] [CrossRef]
- CopyCutterTM EPI400TM. Available online: https://www.yumpu.com/en/document/read/37026343/protocol-for-copycuttertm-epi400tm-electrocompetent-e-coli- (accessed on 4 April 2023).
- Jacob, F.; Monod, J. Genetic regulatory mechanisms in the synthesis of proteins. J. Mol. Biol. 1961, 3, 318–356. [Google Scholar] [CrossRef]
- Lanzer, M.; Bujard, H. Promoters largely determine the efficiency of repressor action. Proc. Natl. Acad. Sci. USA 1988, 85, 8973–8977. [Google Scholar] [CrossRef]
- Valdez-Cruz, N.A.; Caspeta, L.; Pérez, N.O.; Ramirez, O.T.; Trujillo-Roldan, M.A. Production of recombinant proteins in E. coli by the heat inducible expression system based on the phage lambda pL and/or pR promoters. Microb. Cell Fact. 2010, 19, 9–18. [Google Scholar] [CrossRef]
- Guo, J.; Jia, R. A novel inducible expression system for the functional study of toxic gene in bacteria. World J. Microbiol. Biotechnol. 2014, 30, 1527–1531. [Google Scholar] [CrossRef]
- Li, G.Y.; Zhang, Y.; Chan, M.C.Y.; Mal, T.K.; Hoeflich, K.P.; Inouye, M.; Ikura, M. Characterization of dual substrate binding sites in the homodimeric structure of Escherichia coli mRNA interferase MazF. J. Mol. Bio. 2006, 357, 139–150. [Google Scholar] [CrossRef]
- Magnuson, R.; Yarmolinsky, M.B. Corepression of the P1 addiction operon by Phd and Doc. J. Bacteriol. 1998, 180, 6342–6351. [Google Scholar] [CrossRef] [PubMed]
- Wieland, M.; Hartig, J. Improved aptazyme design and in vivo screening enable riboswitching in bacteria. Angew. Chem. Int. Ed. Engl. 2008, 47, 2604–2607. [Google Scholar] [CrossRef] [PubMed]
- Westbrook, A.M.; Lucks, J.B. Achieving large dynamic range control of gene expression with a compact RNA transcription-translation regulator. Nucleic Acids Res. 2017, 45, 5614–5624. [Google Scholar] [CrossRef] [PubMed]
- Li, H.; Hao, C.; Xu, D. Development of a novel vector for cloning and expressing extremely toxic genes in Escherichia coli. Electron. J. Biotechnol. 2017, 30, 88–94. [Google Scholar] [CrossRef]
- Minaba, M.; Kato, Y. High-yield, zero-leakage expression system with a translational switch using site-specific unnatural amino acid incorporation. Appl. Environ. Microbiol. 2014, 80, 1718–1725. [Google Scholar] [CrossRef]
- Nudler, E.; Mironov, A.S. The riboswitch control of bacterial metabolism. Trends Biochem. Sci. 2004, 29, 11–17. [Google Scholar] [CrossRef]
- Mandal, M.; Breaker, R. Adenine riboswitches and gene activation by disruption of a transcription terminator. Nat. Struct. Mol. Biol. 2004, 11, 29–35. [Google Scholar] [CrossRef]
- Aufrère, R.; Tempête, M.; Bohin, J.P. Regulation of expression of the gene for vitamin B12 receptor cloned on a multicopy plasmid in Escherichia coli. Mol. Gen. Genet. 1986, 205, 358–365. [Google Scholar] [CrossRef]
- Verhounig, A.; Karcher, D.; Bock, R. Inducible gene expression from the plastid genome by a synthetic riboswitch. Proc. Natl. Acad. Scie. USA 2010, 107, 6204–6209. [Google Scholar] [CrossRef]
- Kato, Y. Extremely low leakage expression systems using dual transcriptional-translational control for toxic protein production. Int. J. Mol. Sci. 2020, 21, 705. [Google Scholar] [CrossRef] [PubMed]
- Morra, R.; Shankar, J.; Robinson, C.J.; Halliwell, S.; Butler, L.; Upton, M.; Hay, S.; Micklefield, J.; Dixon, N. Dual transcriptional-translational cascade permits cellular level tuneable expression control. Nucleic Acids Res. 2016, 44, e21. [Google Scholar] [CrossRef] [PubMed]
- Lee, Y.J.; Kim, S.J.; Moon, T.S. Multilevel regulation of bacterial gene expression with the combined STAR and antisense RNA system. ACS Synth. Biol. 2018, 7, 853–865. [Google Scholar] [CrossRef] [PubMed]
- O’Connor, C.D.; Timmis, K.N. Highly repressible expression system for cloning genes that specify potentially toxic proteins. J. Bacteriol. 1987, 169, 4457–4462. [Google Scholar] [CrossRef] [PubMed]
- Wang, X.; Fang, C.; Wang, Y.; Shi, X.; Yu, F.; Xiong, J.; Chou, S.; He, J. Systematic comparison and rational design of theophylline riboswitches for effective gene repression. Microbiol. Spectr. 2023, 11, e02752-22. [Google Scholar] [CrossRef]
- Fico, S.; Mahillon, J. TasA-tasB, a new putative toxin-antitoxin (TA) system from Bacillus thuringiensis pGI1 plasmid is a widely distributed composite mazE-doc TA system. BMC Genom. 2006, 7, 259. [Google Scholar] [CrossRef]
- Zhang, Y.; Zhang, J.; Hoeflich, K.P.; Ikura, M.; Qing, G.; Inouye, M. MazF cleaves cellular mRNAs specifically at ACA to block protein synthesis in Escherichia coli. Mol. Cell 2003, 12, 913–923. [Google Scholar] [CrossRef]
- Christensen-Dalsgaard, M.; Gerdes, K. Two higBA loci in the Vibrio cholerae superintegron encode mRNA cleaving enzymes and can stabilize plasmids. Mol. Microbiol. 2006, 62, 397–411. [Google Scholar] [CrossRef]
- Cruz, J.W.; Rothenbacher, F.P.; Maehigashi, T.; Lane, W.S.; Dunham, C.M.; Woychik, N.A. Doc toxin is a kinase that inactivates elongation factor Tu. J. Biol. Chem. 2014, 289, 7788–7798. [Google Scholar] [CrossRef]
- Bahassi, E.M.; O’Dea, M.H.; Allali, N.; Messens, J.; Gellert, M.; Couturier, M. Interactions of CcdB with DNA gyrase. Inactivation of GyrA, poisoning of the gyrase-DNA complex, and the antidote action of CcdA. J. Biol. Chem. 1999, 274, 10936–10944. [Google Scholar] [CrossRef]
- Yuan, J.; Sterckx, Y.; Mitchenall, L.A.; Maxwell, A.; Loris, R.; Waldor, M.K. Vibrio cholerae ParE2 poisons DNA gyrase via a mechanism distinct from other gyrase inhibitors. J. Biol. Chem. 2010, 285, 40397–40408. [Google Scholar] [CrossRef] [PubMed]
- Hallez, R.; Geeraerts, D.; Sterckx, Y.; Mine, N.; Loris, R.; Van Melderen, L. New toxins homologous to ParE belonging to three-component toxin-antitoxin systems in Escherichia coli O157:H7. Mol. Microbiol. 2010, 76, 719–732. [Google Scholar] [CrossRef] [PubMed]
- Hartley, R.W. Barnase and barstar: Two small proteins to fold and fit together. Trends Biochem. Sci. 1989, 14, 450–454. [Google Scholar] [CrossRef]
- De Paepe, B.; Maertens, J.; Vanholme, B.; De Mey, M. Modularization and response curve engineering of a naringenin-responsive transcriptional biosensor. ACS Synth. Biol. 2008, 7, 1303–1314. [Google Scholar] [CrossRef]
- Tuttle, A.R.; Trahan, N.D.; Son, M.S. Growth and maintenance of Escherichia coli laboratory strains. Curr. Protoc. 2021, 1, e20. [Google Scholar] [CrossRef]
- Zorzini, V.; Mernik, A.; Lah, J.; Sterckx, Y.G.; De Jonge, N.; Garcia-Pino, A.; De Greve, H.; Versées, W.; Loris, R. Substrate recognition and activity regulation of the Escherichia coli mRNA endonuclease MazF. J. Biol. Chem. 2016, 291, 10950–10960. [Google Scholar] [CrossRef]
- Nakahira, Y.; Ogawa, A.; Asano, H.; Oyama, T.; Tozawa, Y. Theophylline-dependent riboswitch as a novel genetic tool for strict regulation of protein expression in cyanobacterium Synechococcus elongatus PCC 7942. Plant Cell Physiol. 2013, 54, 1724–1735. [Google Scholar] [CrossRef]
- Hanahan, D. Studies on transformation of Escherichia coli with plasmids. J. Mol. Biol. 1983, 166, 557–580. [Google Scholar] [CrossRef]
- Laemmli, U.K. Cleavage of structural proteins during the assembly of the head of bacteriophage T4. Nature 1970, 227, 680–685. [Google Scholar] [CrossRef] [PubMed]
- Towbin, H.; Staehelin, T.; Gordon, J. Electrophoretic transfer of proteins from polyacrylamide gels to nitrocellulose sheets: Procedure and some applications. Proc. Natl. Acad. Sci. USA 1979, 76, 4350–4354. [Google Scholar] [CrossRef]
- Anindyajati; Artarini, A.A.; Riani, C.; Retnoningrum, D.S. Plasmid copy number determination by quantitative polymerase chain reaction. Sci. Pharm. 2016, 84, 89–101. [Google Scholar] [CrossRef] [PubMed]
- Lee, C.; Kim, J.; Shin, S.G.; Hwang, S. Absolute and relative qPCR quantification of plasmid copy number in Escherichia coli. J. Biotechnol. 2006, 123, 273–280. [Google Scholar] [CrossRef] [PubMed]

| Toxins | Accession Number Uniprot | PfdeA—RSB12 | Ptac—RSB12 | Ptac—RStheo | PBAD—RStheo |
|---|---|---|---|---|---|
| P1Doc | Q06259 DOC_BPP1 | + | - | NT | |
| P1DocH66Y | / | + | + | + | NT |
| EcMazF | P0AE70 MAZF_ECOLI | + | + | + | NT |
| EcMazFE24A | / | + | + | + | NT |
| EcParE2 | A0A0H3JHG3 A0A0H3JHG3_ECO57 | + | - | + | NT |
| FCcdB | P62554 CCDB_ECOLI | + | - | NT | |
| VcHigB2 | Q9KMA6·HIGB2_VIBCH | + | - | + | NT |
| barnase | P00648 RNBR_BACAM | + | - | NT | |
| VcParE2 | Q9KMJ0 Q9KMJ0_VIBCH | - | - | - | + |
| Toxin | Primer | Sequence |
|---|---|---|
| EcMazF-His | MazFHis_F1 | 5′-ccttcttctattgtggatgctttacaatggtaagccgatacgtacccg-3′ |
| MazFHis_R1 | 5′-tccccactcgccagatttacgaagatcagtgatgatgatgatgatggctgc-3′ | |
| His-barnase | Hisbarnase_F1 | 5′-ccttcttctattgtggatgctttacaatgggcagcagccatcacc-3′ |
| Hisbarnase_R1 | 5′-tccccactcgccagatttacgaagagatctttatctgatttttgtaaaggtctgataatggtccg-3′ | |
| barnase-His | barnaseHis_F1 | 5′-ccttcttctattgtggatgctttacaatggcacaggttatcaacacgtttgacgg-3′ |
| barnaseHis_R1 | 5′-tccccactcgccagatttacgaagatcagtgatgatgatgatgatggctgc-3′ | |
| His-VcHigB2 | HisHigB2_F1 | 5′-ccttcttctattgtggatgctttacaatgggcagcagccatcacc-3′ |
| HisHigB2_R1 | 5′-tccccactcgccagatttacgaagatcacgattgctcattgcgc-3′ | |
| VcParE2-His | VcParE2His_F1 | 5′-ccttcttctattgtggatgctttacaatgaaaccatttaatcttaccgtcgccgc-3′ |
| VcParE2His_R1 | 5′-tccccactcgccagatttacgaagatcagtgatgatgatgatgatgtgcg-3′ | |
| P1Doc-His | DocHis_F1 | 5′-ccttcttctattgtggatgctttacaatgaggcatatatcaccggaagaac-3′ |
| DocHis_R1 | 5′-tccccactcgccagatttacgaagatcagtgatgatgatgatgatggctgc-3′ | |
| EcParE2-His | EcParE2His_F1 | 5′-ccttcttctattgtggatgctttacaatgttacccgtgttatggcttgaaagcgc-3′ |
| EcParE2His_R1 | 5′-tccccactcgccagatttacgaagatcagtgatgatgatgatgatggctgc-3′ | |
| FCcdB | CcdB_F1 CcdB_R1 | 5′-cttcttctattgtggatgctttacaatgcagtttaaggtttacacctata-3′ 5′-cactcgccagatttacgaagagatcttatattccccagaacatcaggtta-3′ |
| Plasmids | Description |
|---|---|
| pJYP1_toxin | FdeR—PfdeA—RSB12—toxin in HpaI/XhoI site of pET22b |
| pJYP2_toxin | LacI—Ptac—RStheo—toxin in BglII/XhoI site of pET22b |
| pJYP3_toxin | LacI—Ptac—RSB12—toxin in BglII/XhoI site of pET22b |
| pJYP4_VcParE2 | AraC—PBAD—RStheo—VcParE2 in BglII/XhoI site of pET22b |
| Primer Name | Primer Sequence | Primer Length | Product Size | Source |
|---|---|---|---|---|
| ori.FW | ATACCTGTCCGCCTTTCTCC | 20 nt | 86 bp | [42] |
| ori.RV | GAACGACCTACACCGAACTGAG | 22 nt | 86 bp | [42] |
| dxs.FW | CGAGAAACTGGCGATCCTTA | 20 nt | 113 bp | [43] |
| dxs.RV | CTTCATCAAGCGGTTTCACA | 20 nt | 113 bp | [43] |
Disclaimer/Publisher’s Note: The statements, opinions and data contained in all publications are solely those of the individual author(s) and contributor(s) and not of MDPI and/or the editor(s). MDPI and/or the editor(s) disclaim responsibility for any injury to people or property resulting from any ideas, methods, instructions or products referred to in the content. |
© 2023 by the authors. Licensee MDPI, Basel, Switzerland. This article is an open access article distributed under the terms and conditions of the Creative Commons Attribution (CC BY) license (https://creativecommons.org/licenses/by/4.0/).
Share and Cite
Vandierendonck, J.; Girardin, Y.; De Bruyn, P.; De Greve, H.; Loris, R. A Multi-Layer-Controlled Strategy for Cloning and Expression of Toxin Genes in Escherichia coli. Toxins 2023, 15, 508. https://doi.org/10.3390/toxins15080508
Vandierendonck J, Girardin Y, De Bruyn P, De Greve H, Loris R. A Multi-Layer-Controlled Strategy for Cloning and Expression of Toxin Genes in Escherichia coli. Toxins. 2023; 15(8):508. https://doi.org/10.3390/toxins15080508
Chicago/Turabian StyleVandierendonck, Jessie, Yana Girardin, Pieter De Bruyn, Henri De Greve, and Remy Loris. 2023. "A Multi-Layer-Controlled Strategy for Cloning and Expression of Toxin Genes in Escherichia coli" Toxins 15, no. 8: 508. https://doi.org/10.3390/toxins15080508
APA StyleVandierendonck, J., Girardin, Y., De Bruyn, P., De Greve, H., & Loris, R. (2023). A Multi-Layer-Controlled Strategy for Cloning and Expression of Toxin Genes in Escherichia coli. Toxins, 15(8), 508. https://doi.org/10.3390/toxins15080508

